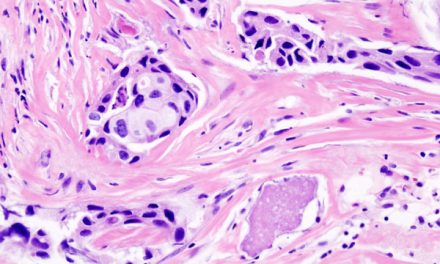
Oncologie : Waiv obtient le marquage CE-IVDR de deux tests de précision

RIHN 2.0 : VitaDX obtient le premier avis favorable du nouveau dispositif
@istock / 174960295
La HAS a donné un avis favorable à la prise en charge dérogatoire de l’utilisation du dispositif médical VisioCyt® Bladder développé par VitaDX, test urinaire alternative à la cytoscopie pour détecter et suivre les cancers de la vessie.
Dans son avis du 5 juin 2025, la HAS explique que « La cytologie urinaire digitalisée et assistée par intelligence artificielle (impliquant le dispositif de diagnostic in vitro VisioCyt® Bladder) est un test d’anatomocytopathologie, non invasif, pré-endoscopique permettant de détecter, à l’aide de l’intelligence artificielle (système figé en utilisation courante), toutes les cellules urothéliales présentes sur une cytologie urinaire digitalisée et de repérer les changements morphologiques invisibles pour l’œil humain. Cet acte permettrait ainsi d’apporter des indications sur l’absence ou la présence suspectée d’un cancer de la vessie, qu’il s’agisse d’une tumeur de bas ou de haut grade. »
Cet avis est la première étape vers la prise en charge effective de cette innovation dans le cadre du dispositif RIHN 2.0. Constituant ainsi le premier acte validé officiellement dans le cadre de la réforme de ce dispositif (voir notre article). En effet, il reste encore au ministère de la Santé et de l’Accès aux soins d’examiner le budget prévisionnel de l’étude ainsi que le coût global de la prise en charge, pour valider la décision définitive sur le remboursement dans le cadre du dispositif RIHN 2.0.
En route pour une utilisation pérenne
Dans son communiqué du 10 juin VitaDX se félicite de cet avis favorable : « Il s’agit d’une excellente nouvelle pour les patients et les professionnels de santé. Cet avis constitue une étape déterminante vers la reconnaissance pérenne de VisioCyt® Bladder. ». Il s’agira maintenant de recueillir les données cliniques et médico-économiques, qui permettront de compléter les éléments nécessaires à une évaluation complète par la HAS en vue d’un remboursement en droit commun.
L’étude prospective, comparative et multicentrique qui prévoit l’inclusion de 2 000 patients atteints de tumeurs de vessie n’infiltrant pas le muscle et suivis avec VisioCyt® Bladder. Elle validera la performance diagnostique du test dans des conditions cliniques réelles, notamment sa sensibilité et sa valeur prédictive négative, en comparaison à la cystoscopie.
Le registre TVNIM et les tests non invasifs
Porté par l’Association Française d’Urologie (AFU), le registre de suivi du cancer de la vessie non invasif sur le plan musculaire (TVNIM-AFU) recueille les données de différents tests non invasifs de détection et caractérisation des tumeurs de la vessie. A ce jour, le registre recueille ainsi les données de 3 autres tests en cours d’évaluation :
- Fabriqué par Cepheid et proposé par le laboratoire Eurofins Biomnis, le test Xpert® Bladder Cancer Monitor est un test urinaire moléculaire non-invasif, destiné au suivi des patients traités pour une TVNIM. Le test Xpert® Bladder Cancer Monitor mesure l’expression par RT-PCR de 5 ARNm cibles dans un échantillon d’urine à l’aide d’une cartouche close.
- Conçu et commercialisé par Oncodiag, le test Urodiag®, est proposé par le laboratoire Cerba (entité du groupe Cerba Healthcare). Le principe du test Urodiag® est de rechercher directement, à partir de l’étude d’un échantillon d’urine, des altérations moléculaires par biologie moléculaire (traces d’ADN des cellules cancéreuses, de protéines, etc.). Le test est basé sur la co-amplification de marqueurs d’altération de l’ADN (mutation et méthylation) par PCR multiplexe, ceux-ci étant comparé à ceux du prélèvement effectué au diagnostic.
- Nucleix, en partenariat avec Inovie, développe quant à lui, le test urinaire Bladder EpiCheck®. Il est basé sur la recherche dans l’urine des anomalies des marqueurs épigénétiques (15 marqueurs de méthylation des gènes) que l’on retrouve assez précocement dans les cancers de la vessie.